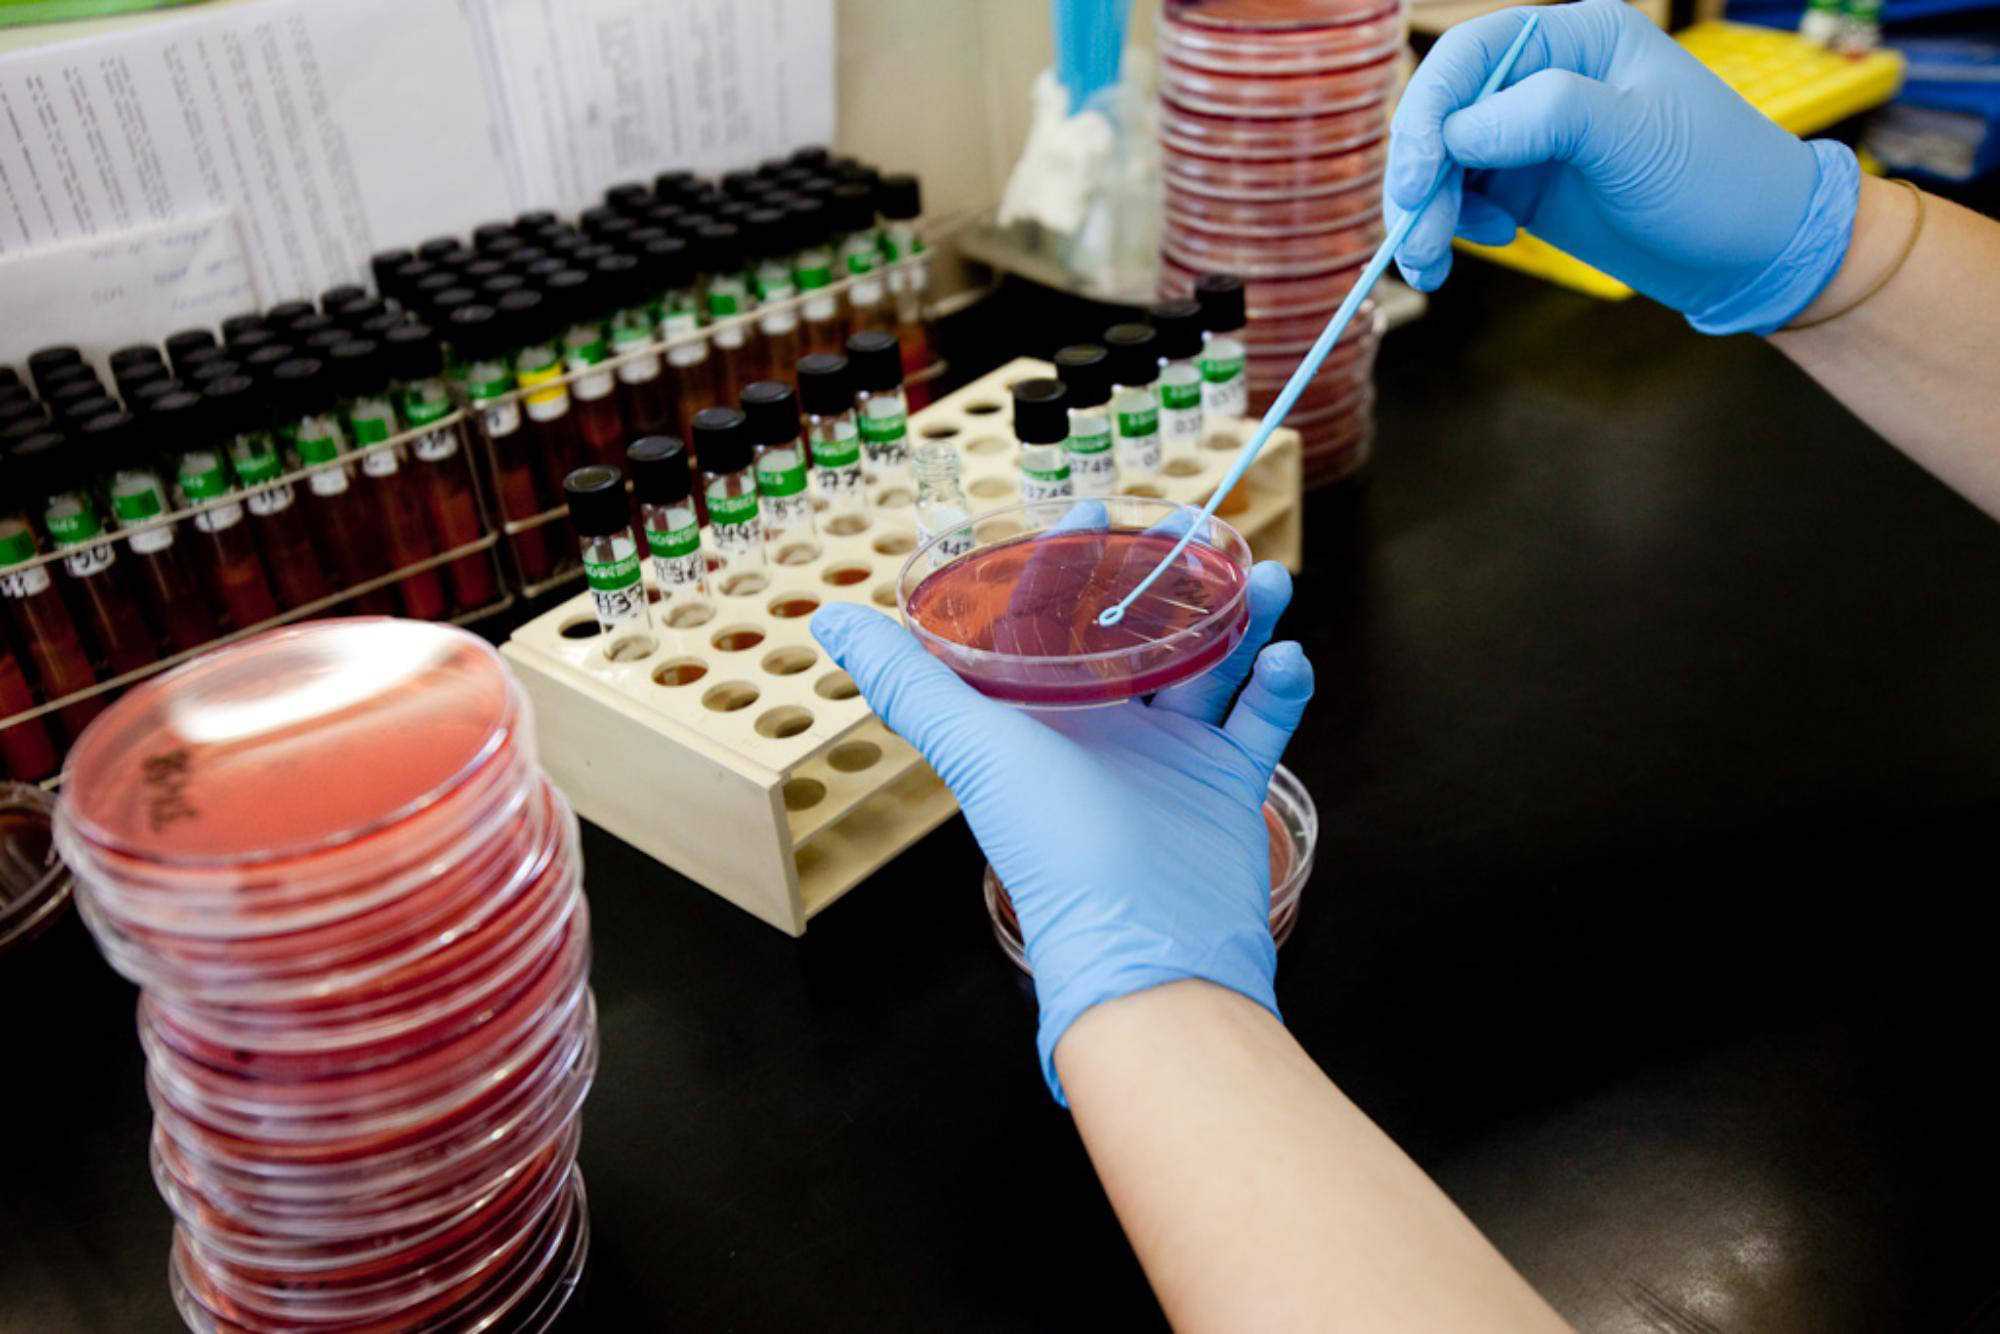
Laboratori del Trueta

Galeria de fotos d'ara i d'abans
Més per descobrir
Segueix endinsant-te en la història del Trueta
Fent història
Llegeix tota la història del Trueta en profunditat

Cronologia a través de les dècades
Un recorregut dècada a dècada per la història del Trueta

Arxiu fotogràfic
Galeria de fotos per entendre l’abans i l’ara

Arxiu de vídeos
Un recorregut audiovisual per la memòria del Trueta

Arxiu bibliogràfic
Revistes i publicacions que expliquen una trajectòria de vocació, innovació i humanitat

Veus pel Trueta
Testimonis i vivències a l’Hospital Trueta

Curiositats del Trueta
Descobreix anècdotes viscudes al Trueta des dels seus inicis!

Agenda d'activitats
Actes i esdeveniments dels 70 anys del Trueta.